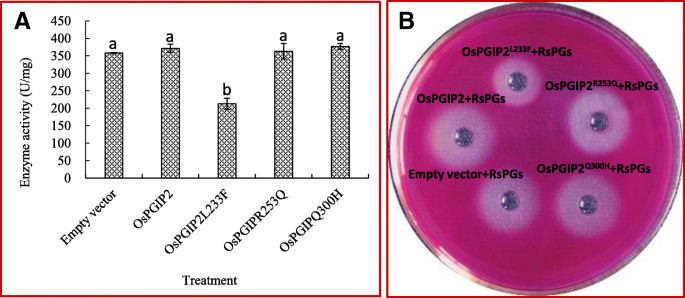

- Original article
- Open access
- Published:
Amino acid substitutions in a polygalacturonase inhibiting protein (OsPGIP2) increases sheath blight resistance in rice
Rice volume 12, Article number: 56 (2019)
Abstract
Background
An economic strategy to control plant disease is to improve plant defense to pathogens by deploying resistance genes. Plant polygalacturonase inhibiting proteins (PGIPs) have a vital role in plant defense against phytopathogenic fungi by inhibiting fungal polygalacturonase (PG) activity. We previously reported that rice PGIP1 (OsPGIP1) inhibits PG activity in Rhizoctonia solani, the causal agent of rice sheath blight (SB), and is involved in regulating resistance to SB.
Result
Here, we report that OsPGIP2, the protein ortholog of OsPGIP1, does not possess PGIP activity; however, a few amino acid substitutions in a derivative of OsPGIP2, of which we provide support for L233F being the causative mutation, appear to impart OsPGIP2 with PG inhibition capability. Furthermore, the overexpression of mutated OsPGIP2L233F in rice significantly increased the resistance of transgenic lines and decreased SB disease rating scores. OsPGIP2L233F transgenic lines displayed an increased ability to reduce the tissue degradation caused by R. solani PGs as compared to control plants. Rice plants overexpressing OsPGIP2L233F showed no difference in agronomic traits and grain yield as compared to controls, thus demonstrating its potential use in rice breeding programs.
Conclusions
In summary, our results provide a new target gene for breeding SB resistance through genome-editing or natural allele mining.
Background
Rice is the most widely-consumed staple food worldwide and feeds over half the world population, particularly in Asia (Kumar et al. 2009; Li et al. 2017). Sheath blight (SB) caused by Rhizoctonia solani, is one of the most serious diseases of rice and recently caused large production losses in the Yangtze River region of China (Wang et al. 2015; Dey et al. 2016). R. solani is a broad-host range saprophyte, and there are no rice cultivars with complete immunity to SB (Eizenga et al. 2002; Hossain et al. 2014; Zhu et al. 2014). Partial resistance exists in some rice cultivars and is conferred by polygenes encoded by quantitative trait loci (QTLs). Introgression of SB resistance via QTLs or by introducing SB-related defense genes has resulted in improved SB resistance in rice (Gaihre et al. 2015; Richa et al. 2016). However, only a few genes or QTLs with high breeding potential have been identified for SB (Zuo et al. 2008, 2011; Zhu et al. 2014).
For successful colonization of plant tissues, pathogens must breach plant cell wall, the first barrier of defense against pathogens. Nearly all fungi, particularly necrotrophic pathogens, must initially secrete PGs to dissolve pectin and related components of plant cell wall (Jones and Jones 1997; Isshiki et al. 2001; Protsenko et al. 2008; Zhang et al. 2014). For example, mutants of Claviceps purpurea lacking the PGs encoded by cppg1 and cppg2 were almost completely nonpathogenic on rye (Oeser et al. 2002).
As a counteroffensive strategy, plants have evolved the ability to secrete PGIPs to reduce the degradation activity of PGs on pectin and related compounds. Complexes between PGIPs and PGs are considered a model system of enzyme-inhibitor interactions at the plant/pathogen interface (Masas-Villamil and Van der Hoorn 2008). It has been previously demonstrated that single amino acid substitutions in PGs may enable the pathogen to escape PGIP recognition; similarly, amino acids substitutions in PGIPs may increase inhibitory properties with respect to PGs (Bishop 2005; Benedetti et al. 2013). In addition to their function in PG inhibition, PGIPs promote the accumulation of oligogalacturonide (OGs) elicitors, which induce host defense responses (Federici et al. 2006; Ferrari et al. 2013). Transgenic plants partially silenced for PGIP genes expression showed enhanced susceptibility to fungal infection, whereas transgenic plants overexpressing PGIP genes displayed more resistance to fungi (Ferrari et al. 2006; Chen et al. 2016; Liu et al. 2016). These studies demonstrate the important roles of PGIPs in the modulation of plant defense to fungal ingress.
Numerous PGIP genes have been identified based on the conserved domain “xxLxLxxNxLxGxIPxxLxxLxxL”; however, only a few have been well investigated (Manfredini et al. 2005; D’Ovidio et al. 2006; Kalunke et al. 2015; Kumar 2017). Some PGIP genes share high sequence identity, whereas others do not (Kalunke et al. 2015). Furthermore, different PGIPs, including members in the same gene subfamily, exhibit diverse inhibitory activities on PGs from same or different pathogens (Desiderio et al. 1997; Stotz et al. 2000; Sicilia et al. 2005). Bean (Phaseolus vulgaris) harbors four PGIPs (PvPGIP1–4) that differ in efficacy against PGs produced by plant pathogens. PvPGIP1 and PvPGIP2 have only eight different amino acids; however, PvPGIP2 has strong PG-inhibiting activity but PvPGIP1 does not (Bishop 2005). In rice, seven OsPGIP genes are reported; four (OsPGIP1-OsPGIP4) are mapped to a 30-kb region on chromosome 5 and the remaining three are mapped to chromosomes 7, 8 and 9 (Janni et al. 2006). OsPGIP genes show various expression patterns in different tissues and organs and are differentially expressed in response to phytohormones or stresses (Janni et al. 2006; Lu et al. 2012; Chen et al. 2016). The expression level of OsPGIP1 in resistant cultivar YSBR1 is highly elevated under different abiotic and biotic stresses (Chen et al. 2016). OsPGIP1 is shown to inhibit PG from Rhizoctonia solani (RsPG) activity (Jang et al. 2003; Janni et al. 2006; Wang et al. 2015), and the overexpression of OsPGIP1 significantly improves rice resistance to SB (Wang et al. 2015; Chen et al. 2016). The OsPGIP homologue OsFOR1 inhibits the activity of PGs from Aspergillus niger (Jang et al. 2003); however, there was no evidence indicating a role in plant defense to fungal pathogens. In general, the roles of OsPGIPs in rice defense against pathogens remains to be elucidated.
In the present study, we showed that OsPGIP2 harbored ten tandem repeats of the canonical 24 amino acid LRR sequence, and each repeat contained the consensus “xxLxLxx” motif; however, unlike OsPGIP1, OsPGIP2 did not inhibit RsPGs. We used site-directed mutagenesis to develop amino acid substitutions in OsPGIP2; we identified one mutant designated OsPGIP2L233F that inhibited RsPGs. OsPGIP2L233F was overexpressed in rice cultivar Xudao No. 3 (cv. XD3) and transgenic rice lines displayed higher SB resistance as compared with the control. Our results indicate that OsPGIP2 is an ideal target for increasing SB resistance in rice.
Results
Characterization of OsPGIP2
OsPGIP2 contains 342 amino acids with ten tandem leucine rich repeat (LRR) units; the deduced protein shows typical PGIP topology with a putative signal peptide of 22 amino acids. The molecular weight and pI of deduced OsPGIP2 were 37.0 kD and 4.73, respectively, and the primary structure was hydrophobic (hydrophobic coefficient of 0.102). OsPGIP2 contained a leucine-rich nuclear export signal sequence (LLLLLSVLLL) and transmembrane helix, which suggests an extracellular location. This was congruent with the predicted localization of the protein, which suggested that OsPGIP2 was secreted. The instability index of OsPGIP2 was 40.41, giving a hint that the protein is stable. The aliphatic index and grand average of hydropathicity suggested that OsPGIP2 is hydrophobic. The predicted solubility of OsPGIP2 overexpressed in E. coli was 0.0%, implying that overexpression products will likely form inclusion bodies (Table 1).
Secondary structure prediction showed that OsPGIP2 contains ɑ-helixes, β-sheets and irregular coils, but no coiled-coil motifs (Table 1 and Fig. 1a). A 3D-model of the tertiary structure predicted by homology modeling indicated that OsPGIP2 has highest identity with Phaseolus vulgaris PGIP2 (PvPGIP2) and could form a cleft that functions to inactivate PGs produced by pathogens (Fig. 1b).
The secondary and tertiary structure of deduced OsPGIP2. a, Secondary structure of OsPGIP2. Lowercase c, h and e represent random coils, α-helices and extended strands, respectively. b, Tertiary structure of OsPGIP2 predicted by homology modeling. α-helices are shown in red, and β-strands are indicated in yellow.
Selection of sites for mutagenesis
Previous studies showed that single amino acid substitutions in PGIPs or PGs could inhibit or change their inherent properties (Leckie et al. 1999; Benedetti et al. 2013). Docking analysis of the interaction between OsPGIP1 or OsPGIP2 and RsPG1 showed that the binding sites of OsPGIP1 or OsPGIP2 are located in the cleft, and that RsPG1 is engaged at the C-terminal edge (Fig. 2). Although preliminary experiments indicated that OsPGIP2 could not inhibit RsPG activity, modeling indicated that OsPGIP2 could form a complex with RsPG1 (Fig. 2).
Comparative analysis of OsPGIP1-RsPG1 and OsPGIP2-RsPG1. a, Cartoon representation of the complex formed by OsPGIP1 (red and yellow) and RsPG1 (cyan blue). Two orthogonal perspectives are shown. b, Surface representation of the complex formed by OsPGIP1 (green) and RsPG1 (cyan). c, Surface representation of the complex formed by OsPGIP2 (yellow) and RsPG1 (cyan). Two orthogonal views are shown.
OsPGIP1, PvPGIP2 and GmPGIP3 (PGIP3 from Glycine max) exhibited strong inhibition for PGs from the corresponding pathogens, such as Sclerotinia sclerotiorum, Fusarium graminearum, Botrytis cinerea and Aspergillus niger (Janni et al. 2006; Maulik et al. 2009). We compared the deduced amino acid sequences of OsPGIP1 and OsPGIP2 and observed that the seventh LRR motif of OsPGIP2 was absent in OsPGIP1 (Janni et al. 2006). Furthermore, OsPGIP2 contained one amino acid substitution (L233) that is a phenylalanine residue in PvPGIP2 and GmPGIP3, which both have strong PGIP activity. The Q253 residue in PvPGIP2 had a major contributory effect on inhibiting the activity of PGs from Fusarium moniliforme, and its replacement with lysine resulted in a dramatic decrease in PGIP activity (Leckie et al. 1999). Conversely, PvPGIP1 acquired the ability to interact with F. moniliforme PGs when the 253rd amino acid residue was mutated from lysine to glutamine; however, the 253rd amino acid in OsPGIP2 was arginine. Furthermore, histidine is present in the active center of many functional PGIPs at the 10th LRR (e.g. PvPGIP2 and GmPGIP3), but OsPGIP2 contains a glutamine at this location (Fig. 3). Based on these findings, L233, R253, and Q300 in OsPGIP2 were selected as the targets to change into phenylalanine, glutamine and histidine, respectively.
Alignment of OsPGIP1, OsPGIP2, PvPGIP2 and GmPGIP3 amino acid sequences. LRR motifs associated with extracellular or extracytoplasmic location are indicated by the consensus XXLXLXX motifs. The amino acids in OsPGIP2 that differ from the corresponding residues in OsPGIP1, PvPGIP2 and GmPGIP3 are bordered with red rectangles. Dashed (−) lines represent gaps in OsPGIP1 and OsPGIP2; dotted lines represent the omitted amino acids in all four PGIPs
PGIP activity of wild-type and mutated forms OsPGIP2
Wild-type OsPGIP2 and the three mutant forms, OsPGIP2L233F, OsPGIP2R253Q, and OsPGIPQ300H, were amplified from cDNA of rice cv. XD3, cloned in pET22b, and sequenced. Sequence analysis confirmed the mutation of L233, R253, and Q300 in OsPGIP2L233F, OsPGIP2R253Q, and OsPGIPQ300H to phenylalanine, glutamine, and histidine, respectively (Fig. 4). We also found two other amino acid substitutions (S17P and N327S) in OsPGIP2L233F and one more substitution (W57A) in OsPGIP2R253Q but they all located in non-activity region of OsPGIP (Fig. 4).
Substituted and mismatched amino acids in wild-type OsPGIP2 and mutated variants OsPGIP2L233F, OsPGIP2R253Q, and OsPGIPQ300H. a, Amino acid sequence of OsPGIP2, OsPGIP2L233F, OsPGIP2R253Q, and OsPGIPQ300H. (i) Signal peptide; (ii), predicted N-terminus of mature proteins; (iii) LRR motifs; and (iv), C-terminus. Black and red rectangles represent targeted and unanticipated mutations, respectively. b, Cartoon model of OsPGIP2. Red and green balls denote mismatched and substituted amino acids, respectively.
Recombinant OsPGIP2, OsPGIP2L233F, OsPGIP2R253Q, and OsPGIPQ300H were extracted, purified, and used to evaluate inhibition of RsPGs (Chen et al. 2016). OsPGIP2 and mutant derivatives were insoluble when overproduced in E. coli BL21; however, after disrupting the bacterial cells by sonication and refolding the proteins, they were used in the reduced sugar and agar diffusion assays (Fig. 5). Except for OsPGIP2L233F protein, which resulted in a reduction of 40.65% of RsPG activity, OsPGIP2, OsPGIP2R253Q and OsPGIPQ300H showed no significant inhibiting activity on RsPGs. In the agar diffusion assay, it was clearly evident that the diameter of the diffusion ring surrounding OsPGIP2L233F plus RsPGs was smaller than the other recombinant protein/RsPG mixtures (Fig. 5b).
Reduced sugar and diffusion assays for inhibition of RsPG activity. OsPGIP2 and mutant forms (OsPGIP2L233F, OsPGIP2R253Q, and OsPGIP2Q300H) were overproduced in E. coli BL21 and assayed for inhibition of RsPGs. a, The reduced sugar assay; b, The agar diffusion assay. Different lowercase letters on the bar show significant statistical difference between treatment and control at 5% significance level. Each bar represents the average and standard deviation of at least three samples.
Overexpression of OsPGIP2 L233F in rice increases SB resistance
PGIP activity assays suggested that OsPGIP2L233F might be utilized in transgenic rice to increase resistance to tissue degradation by RsPGs, thereby improving resistance to R. solani. To test this hypothesis, we overexpressed the mutant gene OsPGIP2L233F in cv. XD3, which is susceptible to R. solani and widely planted in the Jiangsu province of China. Thirty independent transgenic plants were obtained by Agrobacterium-mediated transformation, and the introduction of OsPGIP2L233F was indirectly confirmed by PCR using primers specific to the HPT gene (Additional file 1: Figure S1). Six lines with a single copy of the transgene (Trans 03, 08, 10, 17, 22, and 29) were identified by analyzing the segregation of T1 plants relative to T0 lines; a 3:1 ratio was considered evidence for a single copy of the introduced transgene (Additional file 2: Table S1). Three lines, Trans 08, 17, and 22, retained the typical agronomic traits of wild-type plants and were developed into homozygous lines. The homozygous lines showing strong expression of OsPGP2L233F were selected for further experiments (Fig. 6a).
Analysis of transgenic lines expressing OsPGIP2L233F. a, Relative expression level of OsPGIP2 in wild-type cv. XD 3 and the six transgenic lines (Trans 03, 08, 10, 17, 22, and 29) containing OsPGIP2L233F. b, Content of reducing sugars in wild-type and transgenic rice lines (Trans 08, 17, and 22); seedlings were immersed in a solution containing RsPGs. c, Cell membrane damage (%) as measured by electrical conductivity in wild-type and transgenic plants (%). d, Disease rating scores in wild-type and transgenic lines inoculated with R. solani YN-7. Different lowercase letters on the column show significant statistical difference between treatment and control at 5% significance level. Each bar represents the average and standard deviation of at least three samples.
PGs, from the pathogenic agents, generally function in resolving polysaccharide into reducing sugar, resulting in the damage of cell walls and membranes of plants. For testing the ability of transgenic plants against RsPGs, we immersed the rice sheath into the RsPGs solution, and found that the reducing sugar content from three transgenic lines were 0.73 ± 0.02, 0.75 ± 0.02 and 0.80 ± 0.08 mg/mL, respectively, and all significantly lower than that from wild-type plants (1.28 ± 0.04 mg/mL) (Fig. 6b). We also found that the percentage of damaged cell membranes of transgenic lines (ranged from 9.17 ± 0.59 to 10.27 ± 0.74) were significantly lower than that of wild type (15.53 ± 0.75) (Fig. 6c). When homozygous transgenic lines and the wild-type XD 3 were inoculated with R. solani YN-7 at late tillering in field, the OsPGIP2L233F overexpression lines showed significantly lower disease scores (ranged from 5.63 ± 0.05 to 5.86 ± 0.03) than the control (6.78 ± 0.07), reducing the disease score by 0.92 to 1.14 (Fig. 6d). Collectively, these results indicate that OsPGIP2L233F expressed in transgenic plants, inhibited RsPGs, and enhanced rice resistance to sheath blight.
OsPGIP2 L233F has no deleterious effects on rice growth and development
To determine the potential of OsPGIP2L233F for implementation in rice breeding programs, we measured a set of agronomic traits in the three transgenic homozygous lines, Trans 08, 17 and 22. Results showed that there were no significant differences among the transgenic lines and the wild-type cv. XD 3 in agronomic traits, including heading date, plant height, flag leaf length and width, and tiller numbers. Furthermore, no differences were observed between the wild-type and the transgenic lines with respect to yield-associated components, including the number of productive panicles, panicle length, the number of the primary branches, seed number/panicle, grain length and width, and 1,000-grain weight (Fig. 7, Table 2 and Table 3).
Discussion
The PGIP-PG interaction is a classic model system for analyzing the complex evolution of protein inhibition and enzyme recognition in plant-pathogen interactions. In many plant species, such as rice (Janni et al. 2006), wheat (Janni et al. 2006), bean (D’Ovidio et al. 2004), soybean (Kalunke et al. 2014), rapeseed (Hegedus et al. 2008), pepper (Wang et al. 2013) and Arabidopsis (Ferrari et al. 2003), PGIPs exist as a protein family. Pathogens have evolved different PGs to maximize their offensive potential; conversely plants have evolved various PGIPs with different specificities to counteract the diverse forms of PGs existing in nature. Regardless of origin, PGIPs can exhibit different inhibitory activities to the same or different pathogens (Liu et al. 2017). A single PGIP may display different mechanisms of PG inhibition (competitive, non-competitive and mixed) suggesting that the protein is highly versatile in recognizing different epitopes of PGs (Barmore and Nguyen 1985; King et al. 2002; Sicilia et al. 2005). Besides a single or a few amino acid residues, the inhibition specialization of PGIPs were mainly concerned with its binding sites with PGs (Benedetti et al. 2013; Leckie et al. 1999). The low resolution structure of the PvPGIP2-FvPG complex shows that PvPGIP2 contacts the enzyme using the concave surface of its LRR solenoid in a head-to-head orientation. Both the N- and C-terminal perimeters of the active site cleft of FvPG (produced by Fusarium verticillioides) engaged at the PvPGIP2-FvPG complex, whereas CluPG1 from Colletotrichum lupini was engaged only at the C-terminal border (Benedetti et al. 2013). In addition, the loops surrounding the active site cleft of FvPG also performed the function in contact with PvPGIP2 (Benedetti et al. 2013). In our study, we found that OsPGIP2 bound to the loop at the C-terminal edge of RsPG1, but not the active site in the cleft (see Fig. 2c). This means that the inhibitory mechanism of OsPGIP2 for RsPG1 is non-competitive, which is also the case for OsPGIP1 (see Fig. 2b).
Site-directed mutagenesis has shown that the residues involved in the interaction between PGIPs and PGs are located in the concave surface of PGIPs (Spinelli et al. 2009; Benedetti et al. 2011a, 2011b, 2013). A single amino acid substitution allowed PGIPs to acquire or lose recognition for PGs. When eight amino acids of PvPGIP2 were replaced with the corresponding amino acids of PvPGIP1, each mutation caused a decrease in the affinity for PGs in Fusarium moniliforme and Aspergillus niger (Leckie et al. 1999). Among these amino acids, residue Q253 made a major contribution and its replacement with a lysine led to a dramatic reduction in the binding energy of the PvPGIP2-FmPG complex. Conversely, when amino acid K253 was mutated to a glutamine, which is present in PvPGIP2, PvPGIP1 acquired the ability to interact with FmPG (Leckie et al. 1999). In OsPGIP2, the 233rd amino acid may be involved in PGs inhibition. When the leucine located in the seventh LRR was substituted with phenylalanine, OsPGIP2 acquired inhibitory activity for RsPGs and reduced enzyme activity by over 40% (see Fig. 5). However, when the L233 was substituted with phenylalanine, P17 in signal peptide area and N327 in the C-terminal were substituted with proline and serine respectively at the same time. Whether the substitution of non-target amino acids in the mutant would enhance or weaken its inhibitory effect on RsPGs remains to be further verified. Certainly, many researchers thought that the amino acids of PGIPs involved in the interaction of PGIPs-PGs were located in the concave surface, which was consist of the β-sheet B1, but not in other domains (Leckie et al. 1999; Federici et al. 2001; Benedetti et al. 2011a, 2011b; Kalunke et al. 2015). This statement was supported further by the desolvation energy calculations and alanine scanning assay (Casasoli M et al., 2009).
Many PGIP genes have been transferred into other crop species and overexpression has enhanced disease resistance (Ferrari et al. 2012; Bashi et al. 2013; Kalunke et al. 2015; Wang et al. 2015; Chen et al. 2016). Previous studies reported that overexpression of OsPGIP1 and OsPGIP4 in rice resulted in an increase in disease resistance for SB and bacterial leaf streak, respectively (Wang et al. 2015; Chen et al. 2016; Feng et al. 2016). In this study, we found that OsPGIP2 had no inhibitory for RsPGs unless L233 was substituted with phenylalanine. Overexpression of OsPGIP2L233F in the commercially susceptible japonica cv. XD 3 enhanced resistance to sheath blight in the field and reduced the tissue degradation capability of RsPGs (Fig. 5). Furthermore, compared to wild-type plants, the overexpression OsPGIP2L233F had no impact on morphological and developmental traits associated with yield. In conclusion, OsPGIP2L233F has important practical implications for improving SB resistance in rice.
Materials and methods
Plant materials and growth conditions
Seeds of cv. XD3 and its transgenic derivatives were surface-sterilized before germination by incubating in sodium hypochlorite (0.5% v/v) for 10 min, then rinsed thoroughly in sterile water. Rice seedlings were grown in the greenhouse with a 14 h photoperiod at 25 °C, and seedlings at the five-leaf stage were selected for DNA and RNA extraction. The plants used for inoculation were sown in the field with normal nutrient and water management.
Nucleic acid extraction and gene cloning
Genomic DNA was extracted using the Plant DNA Isolation Kit (Sigma). Total RNA was extracted using the RNAiso Plus reagent according to the manufacturer’s instruction (Takara). First strand cDNA synthesis was conducted using PrimeScript II reverse transcriptase as recommended (Takara). Full-length OsPGIP2 was obtained by PCR with the primers OsPGIP2-F (5′-ATACACGGCATTGCATGCAC-3′) and OsPGIP2-R (5′-CTTACACTCGTTCTCCGTAC-3′) and both genomic DNA and cDNA were used as templates. The amplification conditions were as follow: 5 min at 94 °C; 30 cycles at 94 °C for 30 s, 62 °C for 30 s, and 72 °C for 1 min; and a final step at 72 °C for 7 min. PCR products were amplified and ligated into pMD19-T for sequencing. Three clones of OsPGIP2 were independently sequenced using an automated DNA sequencer (ABI PRISM™ 3730XL DNA Analyzer). Sequence reads were assembled by BioEdit 5.0.9 (Hall 1999).
Sequence analysis
Bioinformatic analyses of open reading frames (ORFs), introns, exons, deduced amino acid sequences, molecular weights, and pIs were performed using the Vector NTI Suite 8.0 software package. Gene ontology was predicted using PredictProtein (https://www.predictprotein.org/). Identification of signal peptide cleavage sites was performed using the online tool (http://www.cbs.dtu.dk/services/SignalP/) (Bendtsen et al. 2004). The solubility, hydropathicity, instability, estimated half-life and the aliphatic index of the recombinant protein were predicted using tools Recombinant Protein Solubility Prediction (http://biotech.ou.edu/) (Diaz et al. 2009) and ExPASy ProtParam tool (http://au.expasy.org/tools/protparam.html) (Gasteiger et al. 2005). Transmembrane helices and subcellular localization analysis were performed using DTU Bioinformatics Prediction Servers (http://www.cbs.dtu.dk/services/). Secondary and tertiary structures of deduced proteins were predicted using HNN SECONDARY STRUCTURE PREDICTION METHOD (http://npsa-pbil.ibcp.fr/cgi-bin/npsa_automat.pl? page=/NPSA/npsa_hnn.html) (Combet et al. 2000) and SWISS-MODEL (http://swissmodel.expasy.org/) (Arnold et al. 2006), respectively. Protein-protein docking was predicted using Cluspro 2.0 (https://cluspro.bu.edu/).
Site directed mutagenesis
Primers OsP2-F (5′-ATACACGGCATTGCATGCAC-3′) and OsP2-R (5′-CTTACACTCGTTCTCCGTAC-3′) were used to amplify full-length OsPGIP2. OsP2L233F-F (5′-TGCTGGCGGCGGCGAACCTGGCGTTCGT-3′)/OsP2L233F-R (5′- GAACGCCAGGTTCGCCGCCGCCAGCAGGTCCGC-3′), OsP2R253Q-F (5′-CGGCGGTGTTCCGGCGGGCACAATAC-3′)/OsP2R253Q-R (5′- ACAGGTCCACGTATTGTGCCCGCCG-3′) and OsP2Q300H-F (5′-TGCATACGTTCAACGTCAGCTACAACAAGA-3′)/OsP2Q300H-R (5′-TGTTGTAGCTGACGTTGAACGTATGCAG-3′) were designed to introduce mutations in OsPGIP2 at the 233th (L233F), 253th (R253Q) and 300th (Q300H) amino acid residues, respectively. The mutated genes were sequenced to confirm the desired mutations.
Overproduction of OsPGIP2 and mutant derivatives in Escherichia coli
For overexpression in E. coli, full-length OsPGIP2 encoding the mature protein and mutant forms were amplified using primers OsP2-PE-F (5′-ttcCATATGTGACCATGGATGTGAAGCTCC-3′, NdeI site is underscored)/OsP2-PE-R (5′-ccgCTCGAGAGTATTATTTATCGACGACGGCA-3′, XhoI site is underscored). Products were digested using NdeI and XhoI and subcloned into the protein expression vector pET-22b (+) to generate His-tagged fusion protein expression construct; these constructs were then introduced into E. coli strain BL21 for overexpression as fusion proteins after induction with isopropyl β-D-1-thiogalactopyranoside. E. coli BL21 cells were harvested by centrifugation at 10,000 rpm for 10 min at 4 °C and then disrupted by sonication at 200 W (Chen et al. 2016). Refolding of recombinant OsPGIP2 and mutant forms present in protein inclusion bodies was performed as described by De Bernardez (1998). Inclusion body proteins were acquired and purified by centrifuging at 12,000 rpm for 10 min at 4 °C, washing with 1% TritonX-100, and then solubilized at Tris buffer containing 8 M urea (pH 8.0). After being agitated intensely for 2–3 h, the mixture was centrifuged at 12,000 rpm for 10 min at 4 °C, and phosphate buffer solution was added into the supernatant and the mixture was loaded dialysis bag to dialyze for 20 h at 4 °C. Recombinant His-tagged fusion proteins were purified and collected according the manufacturer’s instructions for His-Bind Resin (Novagen); proteins were then lyophilized and stored at − 70 °C until needed.
Inhibiting activities of OsPGIP2 and its mutations on RsPGs
The extraction and purification of RsPGs from R. solani was performed as described previously (Chen et al. 2010). The inhibition of RsPG activity by OsPGIP2 and mutant proteins was evaluated using the reduced sugar assay and diffusion assays (Chen et al. 2016; Taylor and Secor 1988). In the reduced sugar assay, 2.0 mL of 0.1 g OsPGIP2 or mutated protein was added to mixtures containing 0.5 mL of RsPGs at 0.2 g/mL, 0.5 mL of 0.25% polygalacturonic acid (Sigma) in 50 mM sodium citrate buffer at pH 5.0, and 1 mL redistilled water. This solution was incubated at 37 °C for 1 h, 2.5 mL of dinitrosalicylate was added, and the mixture was incubated in boiling water for 10 min. After cooling, the optical density values of solutions were measured by UV spectrophotometry; one enzyme unit was defined as the amount of enzyme required to release 1 μg of reduced sugar at 37 °C in 1 h.
The diffusion assay was also used to evaluate inhibition of RsPG activity by OsPGIP2 and mutant proteins. Wells (5 mm diameter) were excised in medium containing 0.8% type II agarose and 0.5% polygalacturonic acid in 0.1 M NaAC buffer (pH 4.7); RsPGs and OsPGIP2 or mutant proteins were then added to the well. After incubation at 37 °C for 17 h, the medium was stained with ruthenium red (0.05% w/v in water) for 2 h and then rinsed thoroughly with water. The inhibitory activities of OsPGIP2 and mutant proteins were evaluated based on the diameter of the diffusion rings.
Expression of OsPGIP2 L233F in transgenic rice
Full-length OsPGIP2L233F was amplified using primer pairs OsP2-OE-F (5′-ggGGTACCTGACCATGGATGTGAAGCTCC-3′, KpnI site is underscored)/OsP2-OE-R (5′-cGAGCTCAGTATTATTTATCGACGACGGCA-3′, SacI site is underscored) and cloned into the binary vector pCAMBIA 1301. Expression of OsPGIP2L233F was driven by the maize ubiquitin-1 promoter and terminated by the NOS termination sequence in construct pCAMBIA 1301-OsPGIP2L233F. The overexpression construct was introduced into Agrobacterium tumefaciens EHA105 using the freeze-thaw method (Sambrook and Russell 2001) and introduced into rice cv. XD3 via Agrobacterium-mediated transformation (Chern et al. 2005). Transgenic plants were confirmed by PCR using primers HygRT-F (5′-ATTTGTGTACGCCCACAGT-3′) and HygRT-R (5′-GGATATGTCCTGCGGGTAAA-3′), which are specific to the hygromycin phosphotransferase gene (HPT). The quantitative reverse-transcription-PCR primers used in this paper were Osp2-RT-F (5′-GGTCGTCGTTCTTGTGCTCG-3′) and Osp2-RT-R (5′-GGTGGTGTCGTCGCAGGTGA-3′), which resulted in a fragment of 190 bp. The PCR primers specific to OsACTIN1, used as the internal control gene, were according to the report by Chen et al. (2016). Each reaction was repeated three times. Two biological replicates for each sample were included.
Evaluation of SB resistance and agronomic traits in transgenic lines
Twenty T2 homozygous plants originating from each T1 parental line were planted in the field and screened at the seedling stage. DNA extracted from leaf sections was used as a template to detect OsPGIP2L233F with primers HygRT-F/HygRT-R. Homozygous transgenic lines and wild-type cv. XD3 were planted in the field in a completely randomized design with three replications for evaluation of agronomic traits including heading date, plant height, flag leaf length and width, tiller number, number of productive panicles, panicle length, number of primary branches, seed numbers/panicle, grain length, grain width, and 1,000-grain weight (1,000 GW). All traits were measured as described by Zuo et al. (2007).
To test whether OsPGIP2L233F expression increased resistance to tissue degradation caused by the RsPGs, a tissue necrosis assay was performed as described previously (Chen et al. 2017). Sheaths of rice seedlings were cut into 2 mm2 segments, immersed in the solution containing RsPGs, and then evaluated for reducing sugar content and electrical conductivity. The virulent R. solani YN-7 was used to inoculate transgenic homozygous lines, and disease severity was evaluated by averaging the disease severity scores on 30 or more tillers (Zuo et al. 2013; Chen et al. 2016).
Statistical analyses
Data were analyzed using the one-way analysis of variance procedure in the SPSS 12.05 program. Mean differences were compared by the Tukey’s test, and P values < 0.05 were considered significant.
Conclusion
In summary, we identified the important amino acid residues of OsPGIP2, and the L233F plays an important role for OsPGIP2 improving SB resistance in rice.
Availability of data and materials
The datasets supporting the conclusions of this article are included within the article and its additional files.
Abbreviations
- kD:
-
Kilodalton
- PGIPs:
-
Polygalacturonase inhibiting proteins
- PGs:
-
Polygalacturonases
- QTL:
-
Quantitative trait loci
- SB:
-
Sheath blight
References
Arnold K, Bordoli L, Kopp J, Schwede T (2006) The SWISS-MODEL workspace: a web-based environment for protein structure homology modelling. Bioinformatics 21:195–201
Barmore CR, Nguyen TK (1985) Polygalacturonase inhibition in rind of Valencia orange infected with Diplodia natalensis. Phytopathology 75:446–449
Bashi ZD, Rimmer SR, Khachatourians GG, Hegedus DD (2013) Brassica napus polygalacturonase inhibitor proteins inhibit Sclerotinia sclerotiorum polygalacturonase enzymatic and necrotizing activities and delay symptom in transgenic plants. Can J Microbiol 59:79–86
Bendtsen JD, Nielsen H, Heijne GV, Brunak S (2004) Improved prediction of signal peptides: signal P 3.0. J Mol Biol 340:783–795
Benedetti M, Andreani F, Leggio C, Galantini L, Di Matteo A, Pavel NV et al (2013) A single amino-acid substitution allows endo-polygalacturonase of Fusarium verticillioides to acquire recognition by PGIP2 from Phaseolus vulgaris. PLoS One 8:1–11
Benedetti M, Bastianelli E, Salvi G, De LG, Caprari C (2011a) Artificial evolution corrects a repulsive amino acid in polygalacturonase inhibiting proteins (PGIPs). J Plant Pathol 93:89–95
Benedetti M, Leggio C, Federici L, De LG, Pavel NV, Cervone F (2011b) Structural resolution of the complex between a fungal polygalacturonase and a plant polygalacturonase-inhibiting protein by small-angle X-ray scattering. Plant Physiol 157:599–607
Bishop JG (2005) Directed mutagenesis confirms the function importance of positively selected sites in polygalacturonase inhibitor protein. Mol Biol and Evol 22:1531–1534
Casasoli M, Federici L, Spinelli F, Di Matteo A, Vella N, Scaloni F, et al. (2009) Integration of evolutionary and desolvation energy analysis indentifies functional sites in plant immunity protein. PNAS 106:7666–7671.
Chen XJ, Chen Y, Zhang LN, Xu B, Zhang JH, Chen ZX et al (2016) Overexpression of OsPGIP1 enhances rice resistance to sheath blight. Plant Dis 100:388–395
Chen XJ, Li LL, Zhang Y, Zhang JH, Ouyang SQ, Zhang QX et al (2017) Functional analysis of polygalacturonase gene RsPG2 from Rhizoctonia solani, the pathogen of rice sheath blgith. Eur J Plant Pathol 149(2):491–502
Chen XJ, Wang YD, Zuo SM, Tong YH, Pan XB, Xu JY (2010) Isolation, purification and characterization of polygalacturonase (PG) from Rhizoctonia solni, the pathogen of rice sheath blight. Acta Phytopathologica Sinica 40(3):276–281
Chern MS, Canlas PE, Fitzgerald HA, Ronald PC (2005) NRR, a negative regulator of disease resistance in rice that interacts with Arabidopsis NPR1 and rice NH1. Plant J 43:623–635
Combet C, Blanchet C, Geourjon C, Deleage G (2000) NPS@: network protein sequence analysis. Trends in Biochem Sci 25:147–150
D’Ovidio R, Raiola A, Capodicasa C, Devoto A, Pontiggia D, Roberti S et al (2004) Characterization of the complex locus of bean encoding polygalacturonase-inhibiting proteins reveals subfunctionalization for defense against fungi and insects. Plant Physiol 135:2424–2435
D’Ovidio R, Roberti S, Di Giovanni M, Capodicasa C, Melaragni M, Sella L et al (2006) The characterization of the soybean polygalacturonase-inhibiting proteins (Pgip) gene family reveals that a single member is responsible for the activity detected in soybean tissues. Planta 224:633–645
De Bernardez CE (1998) Refolding of recombinant protein. Curr Opin Biotech 9:157–163
Desiderio A, Aracri B, Leckie F, Mattei B, Salvi G, Tigelaar H et al (1997) Polygalacturonase-inhibiting proteins (PGIPs) with different specificities are expressed in Phaseolus vulgaris. Mol Plant-Microbe Interact 10:852–860
Dey S, Badri J, Prakasam V, Bhadana VP, Eswari KB, Laha GS et al (2016) Identification and agro-morphological characterization of rice genotypes resistant to sheath blight. Australas Plant Path 45:145–153
Diaz A, Tomba E, Lennarson R, Richard R, Bagajewicz M, Harrison RG (2009) Prediction of protein solubility in Escherichia coli using logistic regression. Biotechnol Bioeng 105(2):374–383
Eizenga GC, Lee FN, Rutger JN (2002) Screening Oryza species plants for rice sheath blight resistace. Plant Dis 86:808–812
Federici L, Caprari C, Mattei B, Savino C, Di Matteo A, De Lorenzo G, et al (2001) Structural requirements of endopolygalacturonase for the interaction with PGIP (polygalacturonase-inhibiting protein). PNAS 98:13425–13430
Federici L, Matteo D, Fernandez-Recio J, Tsernoglou D, Cervone F (2006) Polygalacturonase inhibiting proteins: player in plant innate immunity. Trends Plant Sci 11:65–70
Feng CS, Zhang X, Wu T, Yuan B, Ding XH, Yao FY et al (2016) The polygalacturonase-inhibiting protein 4 (OsPGIP4), a potential component of the qBlsr5a locus, confers resistance to bacterial leaf streak in rice. Planta 243:1297–1308
Ferrari S, Galletti R, Vairo D, Cervone F, De LG (2006) Antisense expression of the Arabidopsis thaliana AtPGIP1 gene reduces polygalacturonase-inhibiting protein accumulation and enhances susceptibility to Botrytis cinerea. Mol Plant-Microbe Interact 19:931–936
Ferrari S, Savatin DV, Sicilia F, Gramegna G, Cervone F, De LG (2013) Oligogalacturonides: plant damage-associated molecular patterns and regulators of growth and development. Front Plant Sci 4:30–38
Ferrari S, Sella L, Janni M, De Lorenzo G, Favaron F, D’Ovidio R (2012) Transgenic expression of polygalacturonase-inhibiting proteins in Arabidopsis and wheat increases resistance to the flower pathogen Fusarium graminearum. Plant Biol 14:31–38
Ferrari S, Vairo D, Ausubel FM, Cervone F, De LG (2003) Tandemly duplicated Arabidopsis genes that encode polygalacturonase-inhibiting proteins are regulated coordinately by different signal transduction pathways in response to fungal infection. Plant Cell 15:93–106
Gaihre YR, Yamagata Y, Yoshimura A, Nose A (2015) Identification of QTLs involved in resistance to sheath blight disease in rice line 32R derived from Tetep. Tropical Agr Dev 59(3):154–160
Gasteiger E, Hoogland C, Gattiker A, Duvaud S, Wilkins R, Appel RD et al (2005) Protein identification and analysis tools on the ExPASY server. In: Walker JM (ed) Proteomics protocols. Humana press, Totowa, pp 571–607
Hall TA (1999) BioEdit: a user-friendly biological sequence alignment editor and analysis program for windows 95/98/NT. Nucleic Acids Symp Ser 41:95–98
Hegedus DD, Li R, Buchwaldt L, Parkin I, Whitwill S, Coutu C et al (2008) Barassica napus possesses an expanded set of polygalacturonase inhibitor protein genes that are differentially regulated in response to Sclerotinia sclerotiorum infection, wounding and defence hormone treatment. Planta 228:241–253
Hossain MK, Tze OS, Nadarajah K, Jena K, Bhuiyan MAR, Ratnam W (2014) Identification and validation of sheath blight resistance in rice (Oryza sativa L.) cultivars against Rhizoctonia solani. Can J Plant Pathol 36:482–490
Isshiki A, Akimitsu K, Yamamoto M, Yamamoto H (2001) Endopolygalacturonase is essential for citrus black rot caused by Alternaria citri but not brown spot caused by Aternaria alternate. Mol Plant-Microbe Interact 14:749–757
Jang SH, Lee BH, Kim CH, Kim SJ, Yim JU, Han JJ et al (2003) The OsFOR1 gene encodes a polygalacturonase-inhibiting protein (PGIP) that regulates floral organ number in rice. Plant Mol Biol 53:357–369
Janni M, Di Giovanni M, Roberti S, Capodicasa C, D’Ovidio R (2006) Characterization of expressed Pgip gene in rice and wheat reveals similar extent of sequence variation to dicot PGIPs and identifies an active PGIP lacking an entire LRR repeat. Theor Appl Genet 113:1233–1245
Jones DA, Jones J (1997) The role of leucine-rich repeat proteins in plant defences. Adv Bot Res 24:90–168
Kalunke RM, Cenci A, Volpi C, O’Sullivan DM, Sella L, Favaron F et al (2014) The pgip family in soybean and three other legume species: evidence for a birth-and-death model of evolution. BMC Plant Biol 14(1):189
Kalunke RM, Tundo S, Benedetti M, Cervone F, De Lorenzo G, D’Ovidio R (2015) An update on polygalacturonase-inhibiting protein (PGIP), a leucine-rice repeat protein that protects crop plants against pathogens. Front Plant Sci 6:1–17
King D, Bergmann C, Orlando R, Benen JA, Kester HC, Visser J (2002) Use of amide exchange mass spectrometry to study conformational changes within the endopolygalacturonase II-homogalacturonan–polygalacturonase inhibiting protein system. Biochemistry 41:10225–10233
Kumar A (2017) Identification of Fusarium moniliformin PG inhibitor using comparative bioinformatics studies of PGIP of Pharsalus vulgaris and its neighbours of LRR superfamily. MOJ Cell Science and Report 4(1):00075
Kumar GM, Mamidala P, Podile AR (2009) Regulation of polygalacturonase-inhibitory proteins in plants is highly dependent on stress and light responsive elements. Plant Omics 2:238–249
Leckie F, Mattei B, Capodicasa C, Hemmings A, Nuss L, De Aracri B et al (1999) The specificity of polygalacturonase-inhibiting protein (PGIP): a single amino acid substitution in the solvent-exposed β-strand/β-turn region of the leucine-rich repeats (LRRs) confers a new recognition capability. EMBO J 18:2352–2363
Li WT, Zhu ZW, Chern MS, Yin JJ, Yang C, Ran L et al (2017) A nature allele of a transcription factor in rice confers broad-spectrum blast resistance. Cell 170:114–126
Liu NN, Ma XW, Zhou SH, Wang P, Sun Y, Li XC, Hou YX (2016) Molecular and functional characterization of a polygalacturonase-inhibiting protein from Cynanchum komarovii that confer fungal resistance in Arabidopsis. PLoS One 11:1–17
Liu NN, Zhang XY, Sun Y, Wang P, Li XC, Pei YK et al (2017) Molecular evidence for the involvement of a polygalacturonase-inhibiting protein, GhPGIP1, in enhanced resistance to Verticillium and Fusarium wilts in cotton. Sci Report 7:39840
Lu LX, Zhou F, Fan XL, Ye SF, Wang L, Chen H et al (2012) Expression profile analysis of the polygalacturonase-inhibiting protein genes in rice and their responses to phytohormones and fungal infection. Plant Cell Rep 31:1173–1187
Manfredini C, Sicilia F, Ferrari S, Pontiggia D, Salvi G, Caprari C et al (2005) Polygalacturonase-inhibiting protein 2 of Phaseolus vulgaris inhibits BcPG1, a polygalacturonase of Botrytis cinerea important for pathogenicity, and protects transgenic plants from infection. Physiol Mol Plant P 67:108–115
Masas-Villamil JC, Van der Hoorn RA (2008) Enzyme-inhibitor interactions at the plant-pathogen interface. Curr Opin Plant Biol 11:380–388
Maulik A, Ghosh H, Basu S (2009) Comparative study of protein-protein interaction observed in PolyGalacturonase-inhibiting protein from Phaseolus vulgaris and Glycine max and PolyGalacturonase from Fusarium moniliforme. BMC Genomics 10(Suppl 3):1–12
Oeser B, Heidrich PM, Muller U, Tudzynski P, Tenberge KB (2002) Polygalacturonase is a pathogenicity factor in the Claviceps pupurea/rye interaction. Fungal Genet Biol 36(3):176–186
Protsenko MA, Buza NL, Krinitsyna AA, Bulantseva EA, Korableva NP (2008) Polygalacturonase inhibiting protein is a structural component of plant cell wall. Biochemistry 73:1053–1062
Richa K, Tiwari IM, Kumari M, Devanna BN, Sonah H, Kumari A et al (2016) Functional characterization of novel chitinase genes present in the sheath blight resistance QTL: qSBR11-1 in rice line Tetep. Front Plant Sci 7(611):244
Sambrook J, Russell D W (2001) Molecular Cloning: A Laboratory Manual, 3rd edn. New York: Cold Spring Harbor Laboratory Press, Cold Spring Harbor
Sicilia F, Fernandez-Recio J, Caprari C, De Leronzo G, Tsernoglou D, Cervone F et al (2005) The polygalacturonase-inhibiting protein PGIP2 of Phaseolus vulgaris has evolved a mixed mode of inhibition of endopolygalacturonase PG1 of Botrytis cinerea. Plant Physiol 139:1380–1388
Spinelli F, Mariotti L, Mattei B, Salvi G, Cervone F, Caprari C (2009) Three aspartic acid residues of polygalacturonase-inhibiting protein (PGIP) from Phaseolus vulgaris are critical for inhibition of Fusarium phyllophilum PG. Plant Biol 11:738–743
Stotz HU, Bishop JG, Bergmann CW, Koch M, Albersheim P, Darvill AG et al (2000) Identification of target amino acids that affect interactions of fungal polygalacturonases and their plant inhibitors. Physiol Mol Plant P 56:117–130
Taylor RJ, Secor GA (1988) An improved diffusion assay for quantifying the polygalacturonase content of Erwinia culture filtrates. Phytopathology 78:1101–1103
Wang R, Lu LX, Pan XB, Hu ZL, Ling F, Yan Y et al (2015) Functional analysis of OsPGIP1 in rice sheath blight resistance. Plant Mol Biol 87:181–191
Wang XJ, Zhu XP, Tooley P, Zhang XG (2013) Cloning and function analysis of three genes encoding polygalacturonase-inhibiting proteins from Capsicum annuum and transgenic CaPGIP1 in tobacco in relation to increased resistance to two fungal pathogens. Plant Mol Biol 81:379–400
Zhang L, Kars I, Essenstam B, Liebrand TWH, Wagemakers L, Elberse J et al (2014) Fungal endopolygalacturonases are recognized as microbe-associated molecular patters by the Arabidopsis receptor-like protein responsiveness to Botrytis polygalacturonases1. Plant Physiol 164:352–364
Zhu YJ, Zuo SM, Chen ZX, Chen XG, Li G, Zhang YF et al (2014) Identification of two major rice sheath blight resistace QTLs, qSB1-1 HJX74 and qSB11 HJX74, in field trials using chromosome segment substitution lines. Plant Dis 98:1112–1121
Zuo SM, Yin YJ, Pan CH, Chen ZX, Zhang YF, Gu SL et al (2013) Fine mapping of qSB-11LE, the QTL that confer partial resistance to rice sheath blight. Theor Appl Genet 126:1257–1272
Zuo SM, Yin YJ, Zhang L, Zhang YF, Chen ZX, Gu SL et al (2011) Effect and breeding potential of qSB-11LE, a sheath blight resistance quantitative trait loci from a susceptible rice cultivar. Can J of Plant Sci 91(1):191–198
Zuo SM, Yin YJ, Zhang L, Zhang YF, Chen ZX, Pan XB (2007) Breeding value and further mapping of a QTL qSB-11 confirming the rice sheath blight resistance. Chin J Rice Sci 21:136–142
Zuo SM, Zhang L, Wang H, Yin YJ, Zhang YF, Chen ZX et al (2008) Prospect of the QTL-qSB-9Tq utilized in molecular breeding program of japonica rice against sheath blight. J Genet Genomics 35(8):499–505
Acknowledgements
No applicable.
Funding
This work was supported by grants from the National Key research and development project (2018YFD0300800), the National Key Technology Research and Development Program of the Ministry of Science and Technology of China (2015BAD01B01–5), the Jiangsu Agricultural Scientific Self-Innovation Fund (CX (16)1001), the Fund of Science and Technology Project of Jiangsu Province (BE2015342), and the Natural Science Foundation of Jiangsu Province (BK20141291).
Author information
Authors and Affiliations
Contributions
XC designed the research plan; XC, YC, LZ, ZH and BH performed the research and analyzed the data; XC wrote the paper; CC, QZ and SZ revised the manuscript. All authors read and approved the final manuscript.
Authors’ information
No applicable.
Corresponding author
Ethics declarations
Ethics approval and consent to participate
Not applicable.
Consent for publication
Not applicable.
Competing interests
The authors declare that they have no competing interests.
Additional information
Publisher’s Note
Springer Nature remains neutral with regard to jurisdictional claims in published maps and institutional affiliations.
Additional files
Additional file 1:
Figure S1. Screening of 30 putative transgenic rice lines transformed with pCAMBIA 1301-OsPGIP2L233F. Lines were screened by PCR for the presence of the HPT gene encoding hygromycin resistance. Abbreviations: M, molecular marker; P, positive control, pCAMBIA 1301; N, negative control, ddH2O; Tr01-Tr30, different transgenic lines. (PDF 195 kb)
Additional file 2:
Table S1. Segregation ratio of the markers (HPT gene) in the transgenic population of overexpressing OsPGIP2L233F. (DOCX 44 kb)
Rights and permissions
Open Access This article is distributed under the terms of the Creative Commons Attribution 4.0 International License (http://creativecommons.org/licenses/by/4.0/), which permits unrestricted use, distribution, and reproduction in any medium, provided you give appropriate credit to the original author(s) and the source, provide a link to the Creative Commons license, and indicate if changes were made.
About this article
Cite this article
Chen, X., Chen, Y., Zhang, L. et al. Amino acid substitutions in a polygalacturonase inhibiting protein (OsPGIP2) increases sheath blight resistance in rice. Rice 12, 56 (2019). https://doi.org/10.1186/s12284-019-0318-6
Received:
Accepted:
Published:
DOI: https://doi.org/10.1186/s12284-019-0318-6